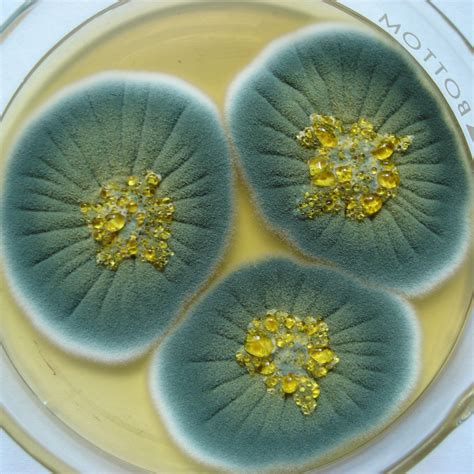
Ilustración de mohos Penicillium en frutas

Introducción a la Patulina en Manzanas
La patulina es una micotoxina producida por ciertos mohos, principalmente del género Penicillium, que puede contaminar diversos alimentos, siendo las manzanas una de las frutas más comúnmente afectadas. La presencia de mohos en frutas, verduras y cereales es un problema significativo en la industria alimentaria, afectando la calidad y seguridad de los productos. Aunque algunas variedades de peras no contienen este contaminante, la manzana es particularmente susceptible a la producción de patulina después de la fermentación.
La patulina es un compuesto que se desarrolla en condiciones específicas, siendo la temperatura y el pH ácido factores críticos. Se ha observado que las concentraciones de patulina son más elevadas en condiciones de pH ácido, lo que subraya la importancia de controlar el ambiente durante el almacenamiento y procesamiento de las manzanas.

Evaluación Toxicológica de la Patulina
La carcinogenicidad de la patulina en humanos no ha sido probada concluyentemente. Sin embargo, estudios en animales han demostrado que la patulina puede ser neurotóxica. Investigaciones iniciales en laboratorio no fueron suficientes para determinar su toxicidad, lo que llevó a una reevaluación del contaminante en 1995. En estudios con ratas, se observó que la patulina se eliminaba del organismo en un plazo de 48 horas, y el 98 por ciento en siete días, sin consecuencias nocivas aparentes, incluso con dosis de hasta 43 µg/kg de peso corporal al día.
Es importante destacar que la presencia de patulina en una fruta no necesariamente indica un riesgo inminente, pero sí demuestra la posibilidad de contaminación. Las condiciones ambientales, tanto con como sin pudrición del centro de la fruta, influyen en la difusión de la patulina. Una parte del contaminante puede haberse difundido incluso a través de tejido aparentemente sano de la manzana.
Factores que Favorecen la Proliferación de Mohos y Patulina
Los mohos responsables de la producción de patulina, como Gloeosporium spp y otras podredumbres secundarias como Penicillium, no se desarrollan hasta después de la recolección de la fruta. Por lo tanto, las medidas de control deben implementarse desde la cosecha hasta el procesamiento.
Las condiciones óptimas para la eliminación de patulina están relacionadas con el control de la temperatura y el pH, especialmente en condiciones de acidez. La fermentación de la manzana puede dar lugar a la formación de patulina, por lo que es crucial gestionar adecuadamente las etapas post-cosecha.
Prácticas de Almacenamiento y Manejo para Minimizar la Patulina
Para prevenir la proliferación de mohos y la consiguiente formación de patulina, se deben seguir estrictas prácticas de manejo e higiene en las instalaciones de almacenamiento. Las áreas de recepción y pesaje deben mantenerse limpias, utilizando mangueras o, preferiblemente, fregando las superficies con agua y jabón. Es fundamental retirar cualquier resto de fruta y hojas, y asegurar que los equipos lavados se sequen antes de su uso.
Control de Condiciones Ambientales
El moho se desarrolla típicamente en ambientes cálidos. Por lo tanto, mantener una temperatura controlada en el almacén es esencial. La refrigeración juega un papel crucial en la mejora de la condición de la fruta y la extensión de su vida útil. Se recomienda que la fruta sea refrigerada en un plazo de 12 horas desde el momento de la selección para minimizar la proliferación de mohos.
La ventilación adecuada y la entrada de luz en el interior del almacén también pueden contribuir a crear un ambiente menos propicio para el desarrollo de mohos. Es importante que la fruta se transporte a las temperaturas óptimas lo más rápido posible, idealmente en un plazo de dos días.
Registro y Monitoreo
Es aconsejable llevar un registro anual de los niveles de contaminantes y realizar un seguimiento periódico de la fruta y su tiempo de conservación, al menos una vez al mes. Esto permite identificar tendencias y tomar medidas correctivas a tiempo. Cualquier fruta que presente signos de daño o podredumbre debe ser separada y manejada adecuadamente para evitar la contaminación cruzada con fruta sana del mismo almacén.
Buenas prácticas de almacenamiento de los productos farmacéuticos
Control de Calidad Durante el Procesamiento
Antes del prensado, es fundamental realizar análisis para detectar la presencia de patulina, preferiblemente en cada lote de fruta. Esto ayuda a prevenir la proliferación de micelios y a garantizar que la fruta cumpla con los estándares de calidad para su procesamiento.
Limpieza y Desinfección de Equipos
Los equipos utilizados en la recepción, pesaje y procesamiento de manzanas, como las cintas transportadoras y las prensas, deben ser limpiados y desinfectados regularmente. Se deben utilizar desinfectantes adecuados y agua potable fría para la limpieza. La frecuencia de limpieza debe ser de al menos una vez por turno o una vez al día, dependiendo de la intensidad de uso.
El objetivo principal es asegurar que la patulina esté por debajo del límite máximo acordado antes de que la fruta sea utilizada para la elaboración de productos, especialmente en el caso de zumos (jugos) que no se fabrican a partir de concentrado. Los procesos térmicos, como la pasteurización, son efectivos para la destrucción de las enzimas y los organismos que producen la descomposición, incluyendo la patulina.

Impacto en la Calidad del Producto Final
El control efectivo de la patulina y otros contaminantes no solo garantiza la seguridad alimentaria, sino que también preserva la calidad organoléptica del producto final. La presencia de mohos y sus toxinas puede afectar negativamente el sabor, el color, la limpidez y otras características sensoriales de los productos derivados de la manzana.